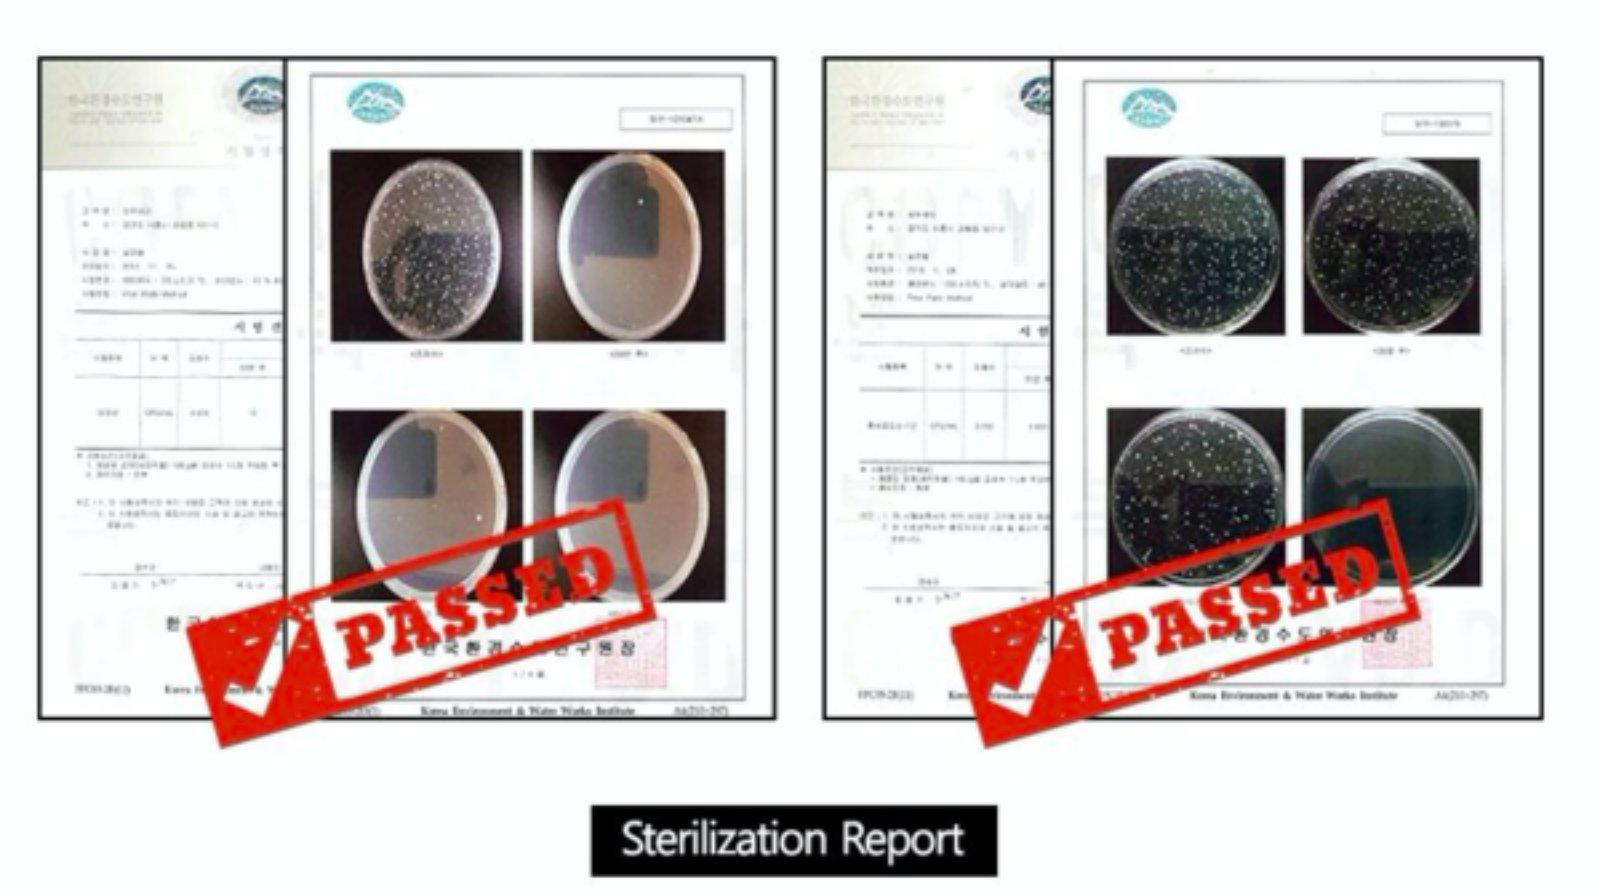
Bebesia Dolphin Filter Shower Head | The Nest Attachment Parenting Hub

Trending Now
Popular Products
Order Cut-Off*
- Pickup: 4 pm
- Delivery: 12 noon
- VIEW ALL BRANDS
- View All Products
-
- Baby Gears
- Go to Baby Gears
- Activity Centers
-
Baby Carriers
- Baby Carriers
- Go to Baby Carriers
- Baby Wrap Carriers
- Hip Seat Carriers
- Bathing Nest-cessities
-
Booster Seats and High-chairs
- Booster Seats and High-chairs
- Go to Booster Seats and High-chairs
- Booster Seats
- High-chairs
-
Diaper Bags and Wet Bags
- Diaper Bags and Wet Bags
- Go to Diaper Bags and Wet Bags
- Diaper Changing Pads
- Diaper Bags
- Wet Bags
- Wipes Containers
-
Kids Bags and Lunchboxes
- Kids Bags and Lunchboxes
- Go to Kids Bags and Lunchboxes
- Kid's Carry-on Bags
- Lunchboxes and Bento Boxes
- Swings, Rockers and Bouncers
-
Sleep Solutions
- Sleep Solutions
- Go to Sleep Solutions
- Sleep Aide
- Sleep Cots and Pods
-
Sterilizers
- Sterilizers
- Go to Sterilizers
- Steam Sterilizers
- UV Sterilizers
-
Strollers, Ride-ons and Car Seats
- Strollers, Ride-ons and Car Seats
- Go to Strollers, Ride-ons and Car Seats
- Car Seats and Car Safety
- Ride-ons
- Strollers and Accessories
-
Swimwear and Gears
- Swimwear and Gears
- Go to Swimwear and Gears
- Headgear
- Swimwear
- Swimming Gear
- Sunglasses
- Towels and Robes
- Toys On-the-Go
-
- Bathing and Grooming
- Go to Bathing and Grooming
- Bathing Nest-cessities
-
Body Wash, Cleansers and Shampoos
- Body Wash, Cleansers and Shampoos
- Go to Body Wash, Cleansers and Shampoos
- Bar Soaps
- No-Rinse Cleansers and Sprays
- Shampoos
- Top to Toe Wash
-
Skin Fresheners, Powders and Sanitizers
- Skin Fresheners, Powders and Sanitizers
- Go to Skin Fresheners, Powders and Sanitizers
- Skin Fresheners
- Powders
- Food Safe Sanitizers
- Diapering and Potty Training
-
Moisturizers and Oils
- Moisturizers and Oils
- Go to Moisturizers and Oils
- Body Lotions and Creams
- Bath and Massage Oils
- Face Creams
- Moisturizing Sprays
- Hair Care
-
Nail Care
- Nail Care
- Go to Nail Care
- Nail Clippers
- Nail Files
- Nail Scissors
- Oral Care
- Respiratory Aide
- Insect Repellents and After Care
- Cotton and Wipes
- Skin Treatments and Prevention
- Sponges and Washcloths
- Towels and Robes
- On-the-Go Grooming
-
- Breast and Bottle Feeding
- Go to Breast and Bottle Feeding
- Bottle Cleaning and Sterilizing
- Bottle Feeding Nest-cessities
- Breast Care
- Breastpumps and Accessories
-
Lactation Support
- Lactation Support
- Go to Lactation Support
- Lactation Drinks
- Lactation Supplements
- Lactation Treats
- Nursing Covers
-
Nursing Pillows
- Nursing Pillows
- Go to Nursing Pillows
- Nursing and Maternity Pillows
- OTG Nursing Pillows
- Nursing Wear
- Special Needs Feeding
-
- Cleaning and Sterilizing
- Go to Cleaning and Sterilizing
-
Area Cleaning and Sanitizing
- Area Cleaning and Sanitizing
- Go to Area Cleaning and Sanitizing
- Alcohol Wipes and Sanitizers
- Area and Surface Sterilizers
- Toy and Surface Cleaning
- Bottle Cleaning and Sterilizing
- Cleaning Tools and Gears
- Laundry Solutions
-
-
- Nest On-the-Go
- Go to Nest On-the-Go
-
Baby Carriers
- Baby Carriers
- Go to Baby Carriers
- Baby Wrap Carriers
- Hip Seat Carriers
-
Breastfeeding On-the-Go
- Breastfeeding On-the-Go
- Go to Breastfeeding On-the-Go
- Nursing Covers
- OTG Nursing Pillows
-
Diaper Bags and Wet Bags
- Diaper Bags and Wet Bags
- Go to Diaper Bags and Wet Bags
- Diaper Changing Pads
- Diaper Bags
- Wet Bags
- Wipes Containers
-
Kids Bags and Lunchboxes
- Kids Bags and Lunchboxes
- Go to Kids Bags and Lunchboxes
- Lunchboxes and Bento Boxes
- Kids Carry-on Bags
- Outdoor Protection
- On-The-Go-Feeding
- On-the-Go Grooming
-
On-the-Go Sleep Solutions
- On-the-Go Sleep Solutions
- Go to On-the-Go Sleep Solutions
- Sleep Cots and Pods
- Sleep Aide
- Pumping On-the-Go
-
Strollers, Ride-ons and Car Seats
- Strollers, Ride-ons and Car Seats
- Go to Strollers, Ride-ons and Car Seats
- Strollers and Accessories
- Ride-ons
- Car Seats and Car Safety
- Sterilizing On-The-Go
-
Sun-Protection Nest-cessities
- Sun-Protection Nest-cessities
- Go to Sun-Protection Nest-cessities
- Sunblocks and After-sprays
- Sunglasses
- Headgear
-
Swimwear and Gears
- Swimwear and Gears
- Go to Swimwear and Gears
- Headgear
- Swimwear
- Sunglasses
- Towels and Robes
- Swimming Gear
- Toys On-the-Go
- Travel Storage Solutions
-
- Nursery and Playroom
- Go to Nursery and Playroom
- Activity Centers
- Baby Proofing
-
Play and Learning Furnitures
- Play and Learning Furnitures
- Go to Play and Learning Furnitures
- Shelves & Bookcases
- Step Stools and Learning Towers
- Tables and Chairs
- Piklers and Attachments
-
Playmats, Rugs and Play Fences
- Playmats, Rugs and Play Fences
- Go to Playmats, Rugs and Play Fences
- Area Rugs and Pillows
- Playmats
- Play Fences
- Swings, Rockers and Bouncers
- Baby Beddings
-
Changing Mats & Accessories
- Changing Mats & Accessories
- Go to Changing Mats & Accessories
- Diaper Changing Mats
- Wipes Warmer
- Waste Disposal
- Crib and Playpen
- Decors, Milestones and Keepsakes
-
Monitors, Cameras and Lighting
- Monitors, Cameras and Lighting
- Go to Monitors, Cameras and Lighting
- Baby Monitors
- Night Lights
- Pillows
-
Sleep Solutions
- Sleep Solutions
- Go to Sleep Solutions
- Sleep Aide
- Sleep Cots and Pods
- Small Storage Solutions
-
Swaddles and Blankets
- Swaddles and Blankets
- Go to Swaddles and Blankets
- Baby Blankets
- Hooded Swaddles
- Toddler Blankets
- Muslin Swaddles
- Wearable Swaddles
- Bathing Nest-cessities
-
- Toddler Feeding
- Go to Toddler Feeding
-
Bibs and Aprons
- Bibs and Aprons
- Go to Bibs and Aprons
- Aprons
- OTG Bibs
- Silicone Bibs
-
Booster Seats and High-chairs
- Booster Seats and High-chairs
- Go to Booster Seats and High-chairs
- Booster Seats
- High-chairs
-
Bowls and Plates
- Bowls and Plates
- Go to Bowls and Plates
- Bowls
- Bowls and Plates w/ Suction
- OTG Bowls and Plates
- Plates
- Utensils
- Feeding Sets
- Table Top Toys
- Rattles and Squeakies
- Food and Snacks
-
Food Prep Solutions
- Food Prep Solutions
- Go to Food Prep Solutions
- Ice Molds
- Food Masher
- Food Scissors
- Food Processors
- Warmers
- Baby Food Storage
- On-The-Go-Feeding
- Placemats and Splashmats
-
Self-feeding
- Self-feeding
- Go to Self-feeding
- Aprons
- Self-feeders
- Self-feeding Utensils
- Drinking Essentials
- Clean-up Nest-cessities
-
- Toys and Learning
- Go to Toys and Learning
- Shop by Age
- Plush Toys and Puppets
- Tummy Time Play Things
- Activity Centers
- Playmats, Rugs and Play Fences
- Swings, Rockers and Bouncers
- Teethers and Grips
- Crib and Stroller Toys
- Learning Visuals and Cards
- Bath Toys
- Table Top Toys
-
Blocks, Stacking and Building
- Blocks, Stacking and Building
- Go to Blocks, Stacking and Building
- Stacking Toys
- Build and Create
- Stack and Balance
- Sensory Toys
- Musical Toys
- Wooden Toys
- Pretend Play
- Arts and Crafts
- Gadgets
- Games and Puzzle
- Gross Motor Skills
- Fine Motor Skills
- Books
- Toys On-the-Go
- Home Learning
- Educational
- Teethers and Grips
-
Play and Learning Furnitures
- Play and Learning Furnitures
- Go to Play and Learning Furnitures
- Shelves & Bookcases
- Step Stools and Learning Towers
- Tables and Chairs
- Piklers and Attachments
-
-
NestMom
- NestMom
- Go to NestMom
-
Health and Beauty
-
Nestmoms Closet
- Post-partum Care
-
Maternity Care
-
Breastfeeding Nest-cessities
- Breastfeeding Nest-cessities
- Go to Breastfeeding Nest-cessities
- Breast Pumps and Accessories
- Breast Care
-
Lactation Support
- Lactation Support
- Go to Lactation Support
- Lactation Drinks
- Lactation Supplements
- Lactation Treats
- Nursing Covers
-
Nursing Pillows
- Nursing Pillows
- Go to Nursing Pillows
- Nursing and Maternity Pillows
- OTG Nursing Pillows
- Nursing Wear
![]()
-
On-the-Go Nestmom
- On-the-Go Nestmom
- Go to On-the-Go Nestmom
- Nestmom Water Bottles
- Nestmom On-the-go Food Storage
- Outdoor Protection
- Sterilizing On-The-Go
-
Baby Carriers
- Baby Carriers
- Go to Baby Carriers
- Baby Wrap Carriers
- Hip Seat Carriers
-
Diaper Bags and Wet Bags
- Diaper Bags and Wet Bags
- Go to Diaper Bags and Wet Bags
- Diaper Bags
- Wet Bags
- Sterilizing On-The-Go
-
Breastfeeding On-the-Go
- Breastfeeding On-the-Go
- Go to Breastfeeding On-the-Go
- Nursing Covers
- OTG Nursing Pillows
![]()
- NestMom Gift Ideas
-
Nest Mom Brands
- Nest Mom Brands
- Go to Nest Mom Brands
- Ava's Kitchen
- Baa Baa Sheepz
- Baby K'tan
- Bamberry Baby
- Beaba
- Belly Bandit
- Biolane
- Bippy
- Bizzi Growin
- Borny
- Buds & Blooms
- Ellana Mineral Cosmetics
- Eucapro
- Gelai.PH
- Health Aid
- Herbilogy
- HoneySuckle
- iflin
- Indigo Baby
- Jele Beautie
- La Señorita
- Little K
- Mama Blends
- Mamaway
- Medela
- Mega-Malunggay
- Mega-Mangosteen
- Milk Easy
- MoMe
- Mommy Treats
- Mother-K
- Mustela
- NatureBond
- Nuud
- PackIt
- ProFreeze
- Sacred Six Months
- Postpartum Care/ Post Episiotomy Sitz Bath for Toilet Seat
- Snug-a-Hug
- Wink
![]()
![]()
-
NestHome
- NestHome
- Go to NestHome
-
Bed and Bath
- Bed and Bath
- Go to Bed and Bath
- Bathing Nest-cessities
-
Sleep Solutions
- Sleep Solutions
- Go to Sleep Solutions
- Sleep Aide
- Sleep Cots and Pods
-
Bed and Bath Linens
- Bed and Bath Linens
- Go to Bed and Bath Linens
- Bath Mats
- Bedding and Seat Protectors
- Beddings and Pillows
- Mommy Robes
- Slippers
- Potty Seats
- Small Storage Solutions
![]()
-
Kitchen and Dining
- Kitchen and Dining
- Go to Kitchen and Dining
-
Booster Seats and High-chairs
- Booster Seats and High-chairs
- Go to Booster Seats and High-chairs
- Booster Seats
- High-chairs
-
Kitchen Appliances
- Kitchen Appliances
- Go to Kitchen Appliances
- Food Processors
- Sterilizers
- Water Purifiers
- Warmers
-
Kitchen and Pantry Organization
- Kitchen and Pantry Organization
- Go to Kitchen and Pantry Organization
- Produce Bags and Wraps
- Air-tight Containers
- Food Pouches
- Ice Molds
- Kitchen Organization
- Zipper Bags
- Kitchen Tools
-
Tableware
- Tableware
- Go to Tableware
- Coasters and Hot Pads
![]()
-
Furnitures and Appliances
- Furnitures and Appliances
- Go to Furnitures and Appliances
- Appliances
- Baby Proofing
-
Monitors, Cameras and Lighting
- Monitors, Cameras and Lighting
- Go to Monitors, Cameras and Lighting
- Baby Monitors
- Night Lights
-
Play and Learning Furnitures
- Play and Learning Furnitures
- Go to Play and Learning Furnitures
- Piklers and Attachments
- Shelves & Bookcases
- Step Stools and Learning Towers
- Tables and Chairs
-
Playmats, Rugs and Play Fences
- Playmats, Rugs and Play Fences
- Go to Playmats, Rugs and Play Fences
- Area Rugs and Pillows
- Playmats
- Play Fences
-
Vacuums and Floor Care
- Vacuums and Floor Care
- Go to Vacuums and Floor Care
- Brooms and Mops
- Vacuums
![]()
-
Laundry, Cleaning and Disinfecting
- Laundry, Cleaning and Disinfecting
- Go to Laundry, Cleaning and Disinfecting
-
Air and Water Purifiers
- Air and Water Purifiers
- Go to Air and Water Purifiers
- Air Purifiers
- Personal Ionizers and Purifiers
- Water Purifiers
-
Area Cleaning and Sanitizing
- Area Cleaning and Sanitizing
- Go to Area Cleaning and Sanitizing
- Alcohol Wipes and Sanitizers
- Area and Surface Sterilizers
- Toy and Surface Cleaning
- Cleaning Tools and Gears
- Hand Soaps
- Laundry Solutions
-
Sterilizers
- Sterilizers
- Go to Sterilizers
- Steam Sterilizers
- UV Sterilizers
- Waste Disposal
![]()
-
Storage and Decor
- Storage and Decor
- Go to Storage and Decor
- Small Storage Solutions
- Labellers and Adhesives
-
Home Fresheners and Fragrance
- Home Fresheners and Fragrance
- Go to Home Fresheners and Fragrance
- Air Fresheners
- Essential Oils and Diffusers
- Decors and Plants
![]()
- Nest Home Brands
![]()
-
NestPantry
-
Shop & Save
- Shop & Save
- Go to Shop & Save
- Clearance Sale
- Gift with Purchase
-
Gift Concierge
- Gift Concierge
- Go to Gift Concierge
-
Gift Registry

-
Gift Card

-
Gift Wrapping

- Cleaning Service
- Rentals
-
Downloadable Checklists
- Downloadable Checklists
- Go to Downloadable Checklists
-
Hospital Bag Checklist

-
Newborn Checklist

- Babyproofing Checklist
- hoNESTlyspeaking
-
Affiliate Program
- Affiliate Program
- Go to Affiliate Program
-
Nestmom Community Ambassador

-
Join Now

-
Login

Sold out

Bebesia Dolphin Filter Shower Head
2 Reviews
|
Ask a question
Vendor:
Bebesia
SKU:
65009236
- ₱4,500.00
- ₱4,500.00
- Unit price
- / per
Please hurry! Only 0 left in stock
Subtotal:
₱4,500.00
Couldn't load pickup availability
Replace your existing shower head with the Bebesia to enjoy clean and purified water best for your baby's sensitive skin. This is made possible by the 450 micron holes in the Bebesia's shower head water panel that enables the release of finer, softer water flow but strong enough to clean baby's skin.




Free Gift Added!
We've added a free gift to your cart.
Free Gift Removed
The free gift has been removed as your cart no longer qualifies.
You Qualify!
You now qualify for a free gift with your order.
Related Products

Recently Viewed Products
- Choosing a selection results in a full page refresh.











